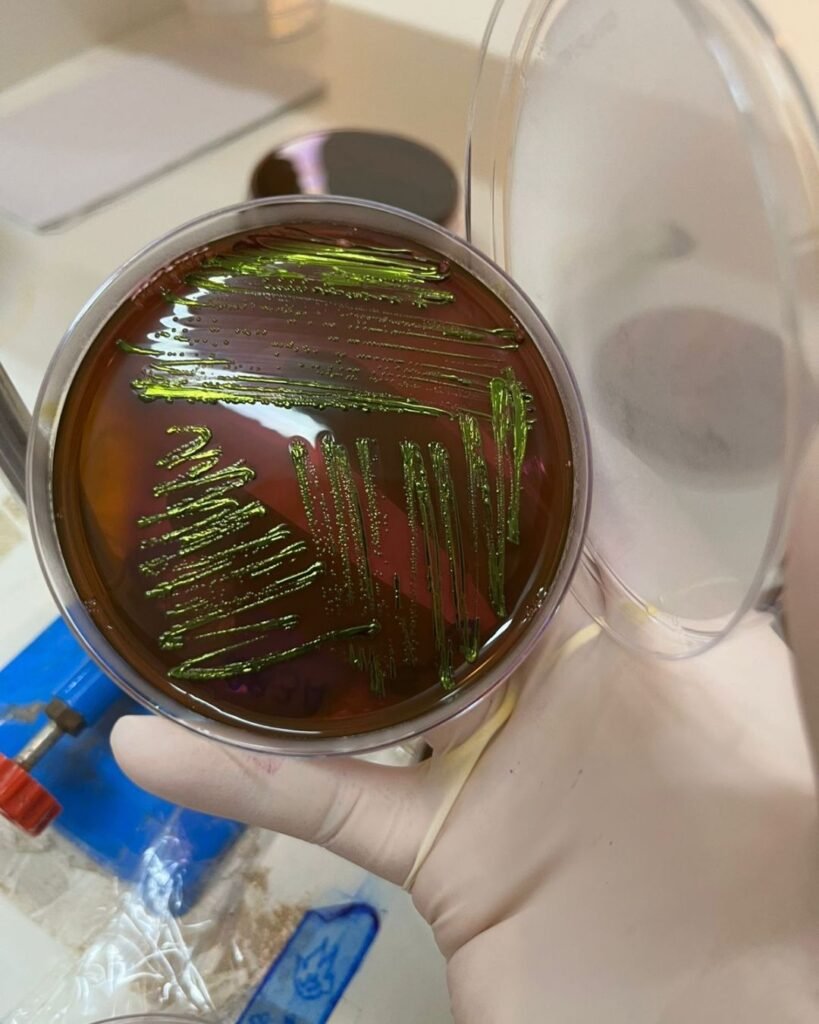
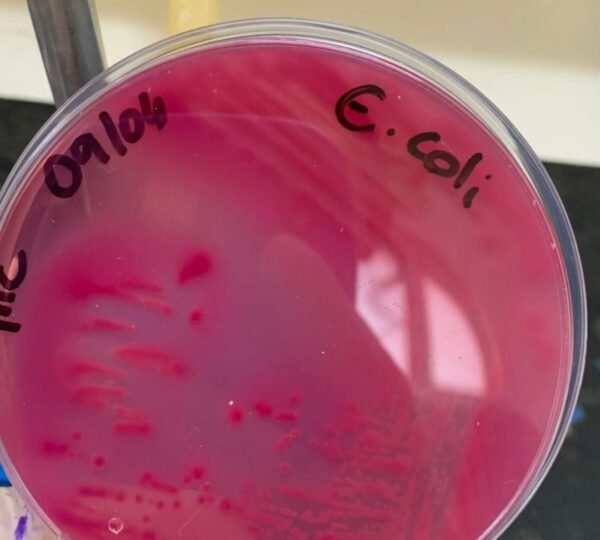

Por Simone Paiva, Analista de Comunicação da FUNDECC – 22 de janeiro de 2026
Estudo da UFLA aponta resistência a antibióticos e circulação entre humanos e animais
Uma bactéria presente no intestino de pessoas e animais, muitas vezes sem causar qualquer problema, pode se transformar em uma ameaça quando se torna resistente a antibióticos. Esse é um dos alertas da pesquisa “Análise genômica comparativa de cepas patogênicas de Escherichia coli isoladas de diferentes hospedeiros sob a perspectiva da Saúde Única”, desenvolvida no Departamento de Medicina Veterinária da Universidade Federal de Lavras (UFLA).
O estudo conta com financiamento da Fundação de Amparo à Pesquisa do Estado de Minas Gerais (FAPEMIG) e é gerenciado pela Fundação de Desenvolvimento Científico e Cultural (FUNDECC).
A pesquisa já aponta dois sinais importantes de atenção: a presença de amostras alarmantemente resistentes a antimicrobianos e indícios de proximidade genética entre cepas isoladas de humanos e de animais, o que sugere a circulação dessas bactérias entre diferentes espécies.
O que é a Escherichia coli e por que ela preocupa?

A Escherichia coli, conhecida como E. coli, é uma bactéria comum no intestino de pessoas e animais. Na maioria das vezes, ela convive de forma natural com o organismo. O problema surge quando entram em cena cepas patogênicas, capazes de causar infecções graves.
Em humanos, a E. coli está entre as principais causas de infecção urinária, além de poder provocar diarreias severas e intoxicações alimentares. Em animais, especialmente na produção leiteira, pode causar mastite em vacas e diarreia em bezerros, trazendo prejuízos econômicos e riscos à saúde.
Segundo a coordenadora do projeto, a professora Elaine Dorneles, a resistência aos medicamentos é um dos pontos mais preocupantes identificados até agora.
“Nós já identificamos amostras resistentes a antimicrobianos, o que dificulta o tratamento tanto de infecções animais quanto humanas”, explica.
Impacto direto na produção: quando a bactéria chega à fazenda



Essa preocupação aparece de forma muito concreta no dia a dia da produção leiteira. A médica-veterinária Maisa S. Gonçalves, pós-doutoranda da UFLA e integrante da equipe do projeto, explica que a Escherichia coli está presente em praticamente todas as propriedades rurais, por ser um coliforme encontrado nas fezes dos animais.
“A E. coli é um microrganismo oportunista. Ela não é, em geral, adaptada à glândula mamária da vaca, mas como o animal é ordenhado todos os dias e o teto fica um período aberto após a ordenha, o contato com barro e fezes favorece a infecção”, explica.
Quando a bactéria causa mastite, os impactos são imediatos e significativos para o produtor.
“Essas mastites costumam ser mais severas, com dor, inflamação e alterações no leite, além de prejuízos econômicos, como perda de produção, descarte de leite e aumento do uso de antibióticos”, completa Maisa.
O que a pesquisa está investigando
O estudo analisa mais de 100 amostras de E. coli, coletadas de diferentes origens: humanos (principalmente casos de infecção urinária), animais de produção como bovinos e búfalos, animais de companhia — especialmente cães — e também animais silvestres.
Essas amostras passam por sequenciamento genético completo, permitindo a comparação do DNA das bactérias. O objetivo é identificar genes ligados à capacidade de causar doença (virulência), à resistência a antibióticos e ao grau de parentesco entre cepas encontradas em diferentes hospedeiros.
De acordo com a professora Elaine Dorneles, os dados já reforçam a necessidade de um olhar integrado sobre o problema:
“As análises genômicas mostram proximidade entre cepas isoladas de diferentes espécies, incluindo humanas e animais. Isso indica que não dá para pensar a saúde de forma separada.”

Saúde Única: quando a saúde é compartilhada
Essa integração é a base do conceito de Saúde Única (One Health), que reconhece que a saúde humana, animal e ambiental estão diretamente conectadas.
Na prática, isso significa que uma bactéria resistente que surge em um animal pode chegar às pessoas por meio do contato direto, do consumo de alimentos — como carnes mal passadas e leite cru, conhecido como artesanal e não pasteurizado —, da higiene inadequada ou do ambiente. Da mesma forma, humanos também podem ser fonte de infecção para os animais com os quais convivem.
“Quando humanos, animais e ambiente compartilham o mesmo espaço, existe uma única saúde. O que acontece com um impacta diretamente o outro”, resume a pesquisadora.
A visão das estudantes: ciência conectada à vida real

A pesquisa também envolve a formação de estudantes de pós-graduação, que atuam diretamente nas análises laboratoriais, genômicas e na interpretação dos dados.
Para a médica-veterinária Jéssica Luana Félix Moreira, o estudo evidencia como humanos e animais estão mais conectados do que se imagina.
“Mesmo analisando amostras de diferentes cidades e de espécies distintas, observamos proximidade genética entre algumas cepas. Isso mostra como a interação entre pessoas e animais pode influenciar a saúde de todos”, destaca.
Já a bióloga Dircéia Aparecida Costa, que estudou cepas associadas à diarreia em bezerros, chama atenção para o impacto direto no campo.
“Em animais muito jovens, como bezerros, algumas cepas de E. coli podem causar quadros rápidos e graves, com risco de morte. Identificar essas bactérias permite orientar melhor o produtor e reduzir perdas”, afirma.
Do laboratório ao campo: pesquisa que vira orientação

Além da produção científica, o projeto tem forte atuação em extensão, por meio do Laboratório Integrado de Sanidade Animal e Saúde Coletiva (LISASC).
O laboratório realiza diagnósticos para produtores rurais e oferece consultoria técnica, indo além do resultado do exame. Casos de mastite, abortos e diarreias estão entre as principais demandas atendidas.
Essa atuação contribui para o uso mais responsável de antibióticos, melhora o bem-estar animal e reduz riscos à saúde humana.
Ciência para prevenir

Embora o estudo ainda esteja em andamento, os resultados já reforçam uma mensagem clara: prevenir é tão importante quanto tratar. Entender como as bactérias circulam entre humanos e animais e como desenvolvem resistência aos antibióticos é fundamental para orientar boas práticas, políticas públicas e escolhas conscientes no dia a dia.
A pesquisa mostra como a ciência desenvolvida na universidade pode sair do laboratório e impactar diretamente a vida das pessoas, dos produtores e da sociedade como um todo.

Deixe um comentário